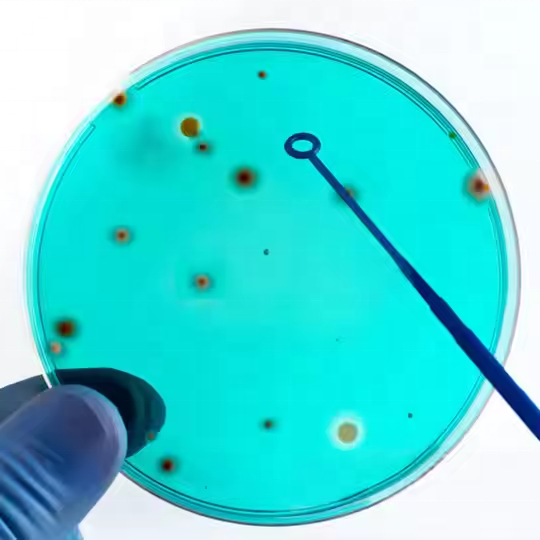

Thuộc tính
Polystyrenetài liệu
Consumbles y tếLoại
ZHEJIANGNơi xuất xứ
disposable pipetteSố Mô Hình
LIQUANNhãn hiệu
OEM, ODM, Dịch vụ tùy chỉnh được hỗ trợ, Dịch vụ OEM hỗ trợ cho serological Pipette, 1ml đến 100ml tất cả cóTùy Chỉnh Hỗ Trợ
Bảo hành:2 năm
Tiêm chủng vô trùng bằng nhựa:Cấy vi khuẩn
Bảo hành:2 năm
Vật liệu:Nhựa PP
Đóng gói:Túi nhựa số lượng lớn, 2000 cái/ctn
Nhựa dùng một lần kim loại inoculat:Vòng tiêm y tế và kim
Phòng thí nghiệm 10ul tiêm Vòng:1ul dùng một lần tiêm vòng lặp
Vòng tiêm chủng:Phòng thí nghiệm 1ul 10ul dùng một lần
Đĩa nuôi cấy tế bào đĩa petri vô trùng:Phòng thí nghiệm nhựa kính petri món ăn di động
Phân loại:Pipet
bán Đơn Vị:Một món hàng
độc gói kích thước:38X24X30 cm
duy nhất tổng trọng lượng:6.000 kg












